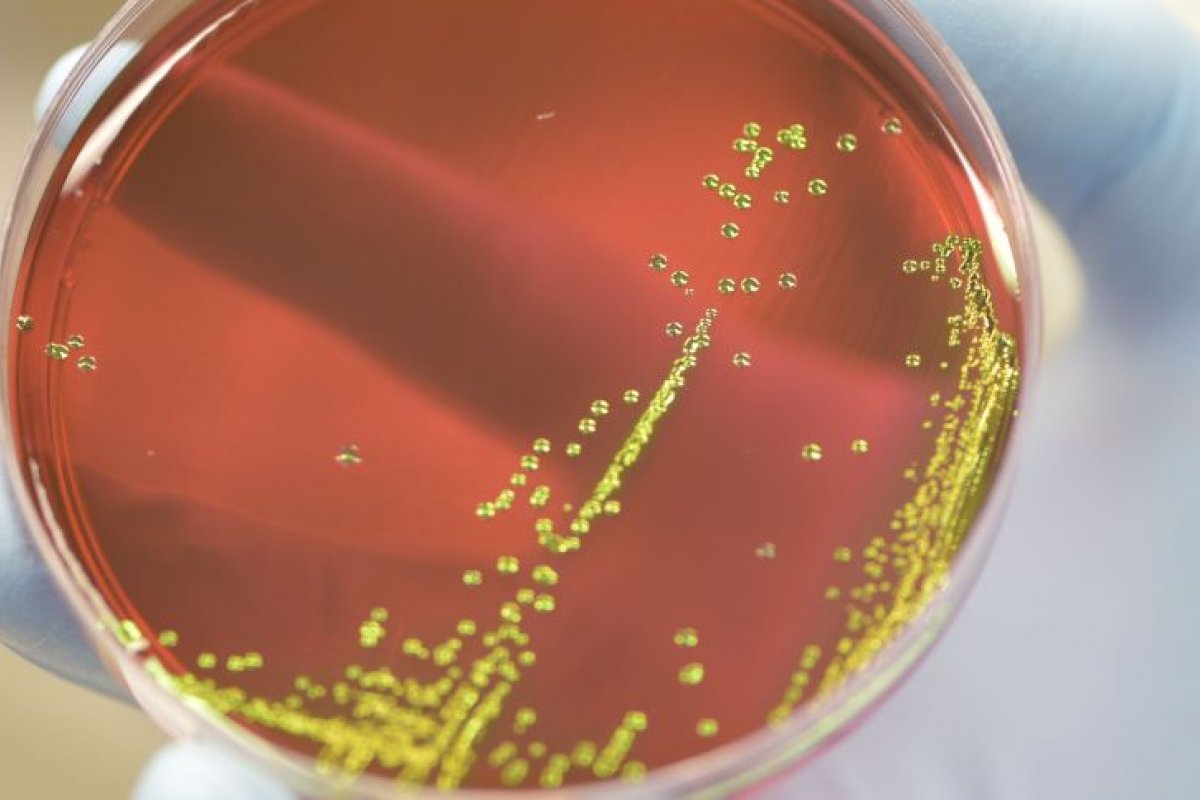
Infecções por superbactérias levaram 1,2 milhão de pessoas à morte em 2019

Infecções por superbactérias levaram 1,2 milhão de pessoas à morte em 2019
Número é maior do que mortes provocadas por Aids ou malária
Foto: Gutemberg Brito/IOC/Fiocruz
Um amplo estudo global sobre superbactérias - bactérias resistentes aos medicamentos - publicado na revista The Lancet, mostra que cerca de 1,2 milhão de pessoas morreram em 2019 devido a infecções bacterianas resistentes aos antibióticos. Esse número é superior às mortes causadas por Aids ou malária, por exemplo.
A análise considerou dados 204 países e territórios e constatou que a resistência bacteriana se tornou uma das principais causas de morte no mundo. O estudo ainda indica que as causas dos óbitos são infecções comuns e tratáveis, como doenças respiratórias e da corrente sanguínea decorrentes da resistência ao tratamento que as bactérias adquiriram.
“Esses novos dados revelam a verdadeira escala da resistência antimicrobiana em todo o mundo e são um sinal claro de que devemos agir agora para combater a ameaça. Estimativas anteriores previam 10 milhões de mortes anuais por resistência antimicrobiana até 2050, mas agora sabemos com certeza que já estamos muito mais próximos desse número do que pensávamos”, afirmou o coautor do estudo, Chris Murray, professor do Instituto de Métricas e Avaliação de Saúde da Universidade de Washington, nos Estados Unidos, em um comunicado.
As estimativas que Murray cita são de um relatório do governo britânico liderado pelo economista Jim O’Neill publicado em 2016 que apontou cerca de 700 mil mortes, por ano, no mundo, devido a infecções causadas por bactérias resistentes.
A partir desse dado, naquela época, os pesquisadores fizeram uma estimativa de que, se não fossem feitas mudanças em nível global, a resistência a antibióticos pode levar à morte de 10 milhões de pessoas por ano a partir de 2050, o que representa uma morte a cada 3 segundos.
“Precisamos aproveitar esses dados para corrigir o curso e impulsionar a inovação se quisermos continuar à frente na corrida contra a resistência antimicrobiana”, disse Murray.


